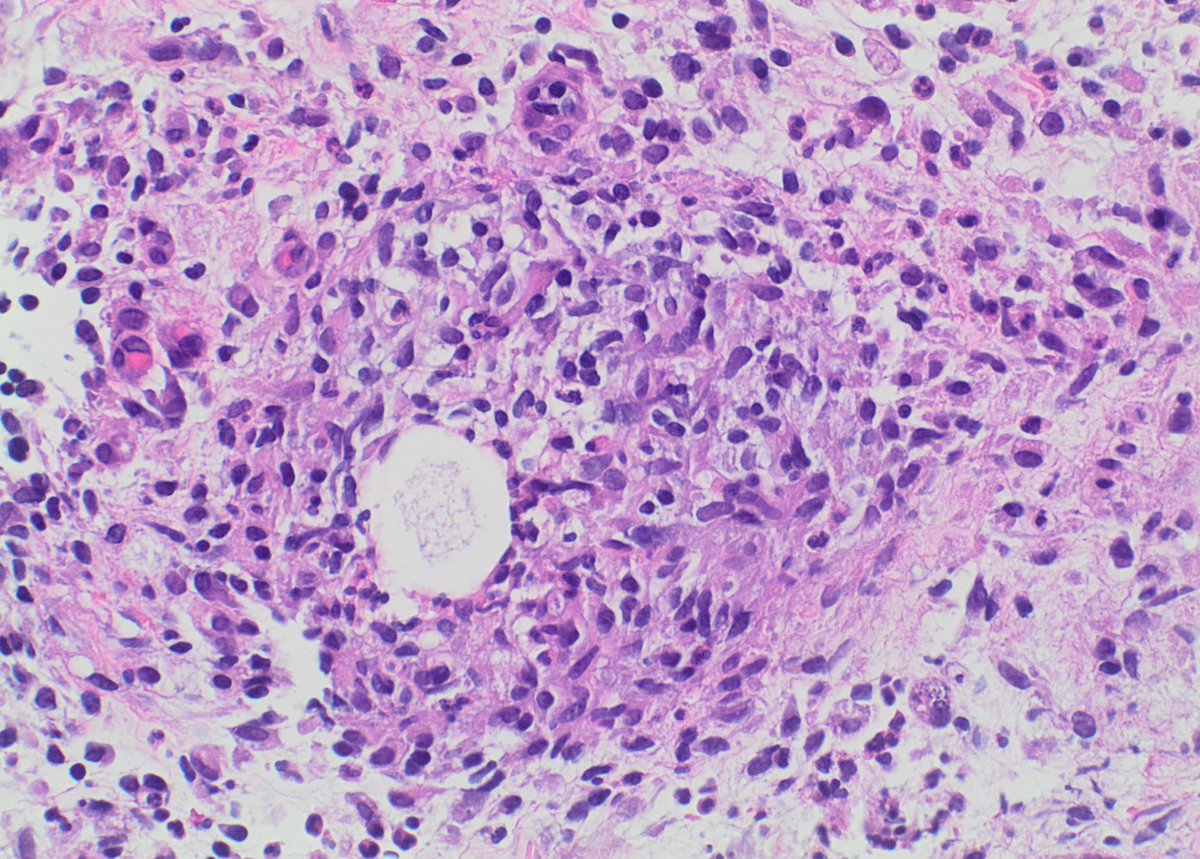
Garrey Faller tweet media
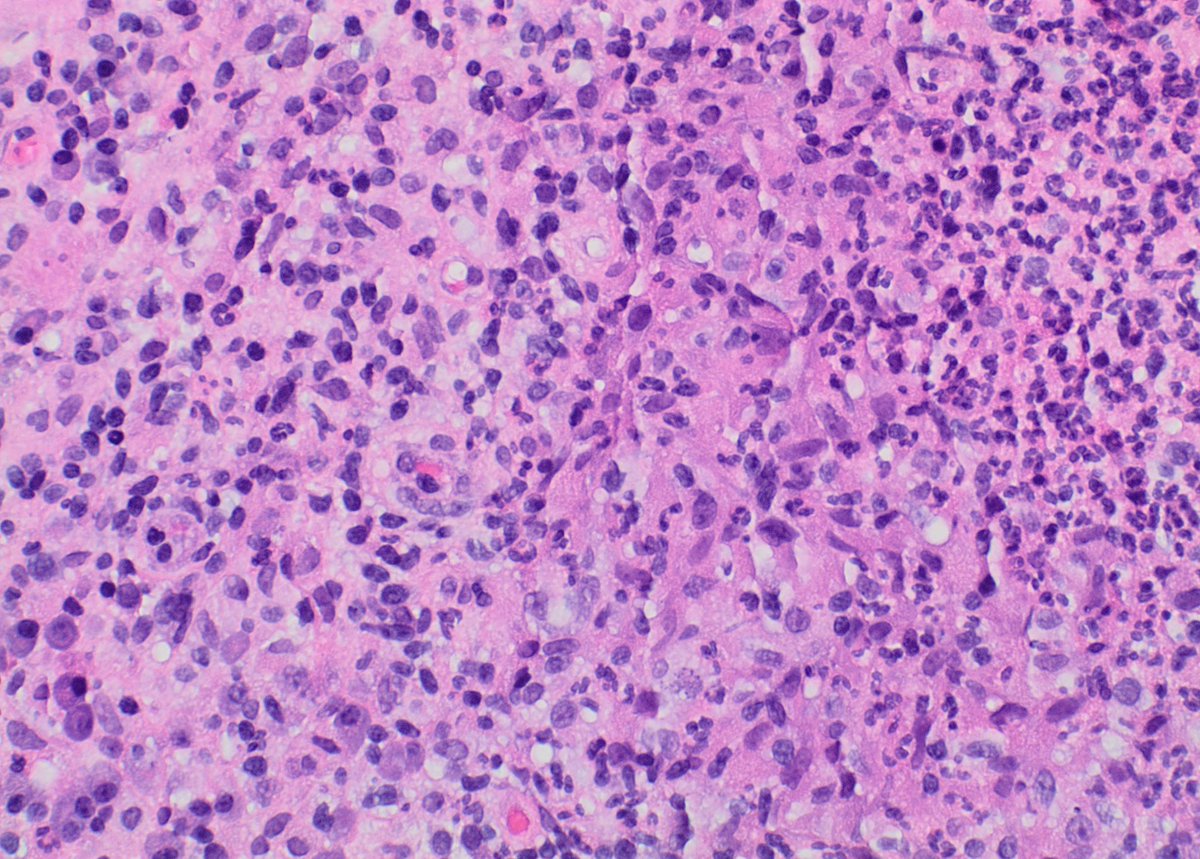
Garrey Faller tweet media

Debasmita Das, MD
194 posts

Debasmita Das, MD
@Debdasmd
GI/Liver Pathology Fellow @BIDMCpath @HarvardMed I@TheUSCAP Ambassador l @pathologist prior RF Delegate l @KMC_Mangalore
Boston, USA Katılım Ekim 2018
651 Takip Edilen919 Takipçiler

@garreyf @debpratik @natasharekhtman @PulmPathSoc @mkbaine @yro854 @JL_Sauter @AndreMo77438628 @thoracicpath @flr7066 @PJoubertPatho @MSKPathology Great question @garreyf ! There’s a very detailed answer to your question here:
pubmed.ncbi.nlm.nih.gov/28777151/
English

Hi all! Common #pulmpath scenario: adult W, smoker, 5 cm lung mass. No known Hx & no lesions elsewhere.❓for #pathologists: is IHC needed here or is this c/w lung primary based on clinical setting & histology? (obvious bait, but good real-life scenario to discuss) #natpathpuzzler


English
Debasmita Das, MD retweetledi

Innocent colonic tubular adenoma, or vicious man-eatin' gator? Maybe some of our #gipath colleagues in Florida could weigh in ... #pathology #PathTwitter


English
Debasmita Das, MD retweetledi

Happy Halloween! Here's a scary targeted liver biopsy. Lesion barely visible at first. Third pic = pankeratin. Did additional stains, and deepers had much more tissue. Fourth pic = INSM1. This was a metastatic small bowel neuroendocrine tumor. #pathology #liverpath #PathTwitter




English
Debasmita Das, MD retweetledi

The wall of this gallbladder shows several TACE spheres trapped in vascular lumens and spilling out into the parenchyma. They're larger and therefore easier to spot than Y90 spheres, which I see more commonly. #pathology #gipath #PathTwitter


English
Debasmita Das, MD retweetledi

I think I stumbled on an interesting Her2 IHC and thought I would share. How would you score? @ADamronMD @LizaMQuintana #breastpath
English
Debasmita Das, MD retweetledi

Thanks Pathologeek. Nice tweetorial @Debdasmd
PATHOLOGEEK@pathologeek_
GASTRIC BIOPSY CHECKLIST Many systems to classify and report gastritis have been developed (Sydney, Houston & OLGA). Regardless of which system you prefer to use, you should always report the next variables. #GIpath #pathology #pathologist #gastritis #tweetorial #DCF
English

@Gagandeepk5MD @ac_pathgal @raghupillappa @HansiniMD @SanicaBheleMD @NupursharmaMD @Sujata_path @JayaVen @SusanKarki777 @AlainCagaanan @Ramavid15 @Drsandeep89 @DonthiDeepak @DrNidhiKataria @DrGeeONE @kkuanMD @TheKarenPinto @ALBoothMD Awesome case!
Brockton, MA 🇺🇸 English

Lung lesion. What stains will you request #lungpath @ac_pathgal @raghupillappa @HansiniMD @SanicaBheleMD @NupursharmaMD @Sujata_path @JayaVen @SusanKarki777 @AlainCagaanan @Ramavid15 @Drsandeep89 @DonthiDeepak @DrNidhiKataria @DrGeeONE @kkuanMD @TheKarenPinto @ALBoothMD @Debdasmd



English

Debasmita Das, MD retweetledi

Hi #pathology residents & fellows..can you guess the immunohistochemical stain and the process?
#PathTwitter #GIpath #liverpath (clue ??😉)

English

✨Another one from the @RaulSGonzalezMD extravaganza✨
Our GI fellow @Debdasmd's strong work on Pancreatic NE tumors
#GIpath
#USCAP2022 #USCAP22

English
Debasmita Das, MD retweetledi

✨ Wednesday evening's #USCAP2022 #USCAP22 poster session ✨
Representing @BIDMCpath are GI path fellow @Debdasmd and PGY-2 resident @HirtChristian
Our trainees do amazing work! 💪

English
Debasmita Das, MD retweetledi

✨Dr K. Krishnamurthy from @BIDMCpath
collaborating with our director of head and neck pathology Dr @MichiyaNishino ✨
#USCAP2022 #USCAP22

English
Debasmita Das, MD retweetledi

✨The @RaulSGonzalezMD poster extravaganza ✨
One with future @BIDMCpath GI attending @YuhoMD
Another with @Mvgs1706 !
#USCAP2022 #USCAP22


English
Debasmita Das, MD retweetledi
Debasmita Das, MD retweetledi

Debasmita Das, MD retweetledi
Debasmita Das, MD retweetledi
Debasmita Das, MD retweetledi